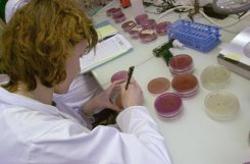

La propagation d'une bactérie mortelle en Allemagne a poussé la Commission européenne à lancer un appel à la vigilance. Sa présence a été confirmée dans des concombres en provenance d'Espagne. Déjà plusieurs personnes sont mortes et des centaines d'autres sont malades
Jeudi 26 mai, des experts allemands ont réussi à identifier la bactérie qui inquiète tant les autorités sanitaires depuis une dizaine de jours. Il s'agit de la Escherichia coli enterohémorragique (Photo AFP), une bactérie que l'on retrouve dans des légumes. D'après les autorités sanitaires allemandes, "les soupçons concernant la source de la maladie se portent sur les concombres" importés d'Espagne, a déclaré Cornelia Prüfer-Storcks, chargée des questions de santé à la Ville-État de Hambourg.
Des conséquences dramatiques
Si les autorités s'inquiètent de la propagation de la maladie, c'est parce qu'elle a déjà causé la mort de deux personnes. Trois autres décès seraient également liés à la bactérie. "Nous nous attendons à perdre des patients" explique le docteur Rolf, un néphrologue de l'hôpital de Hambourg-Eppendorf. L'Union européenne a mis en garde jeudi les voyageurs ayant séjourné en Allemagne depuis la mi-mai et leur a demandé d'être particulièrement attentifs aux symptômes liés à une infection par la bactérie : maux de ventre et de tête violents, diarrhée liquide ou sanglante, saignements du nez. L'UE souligne qu'il est "essentiel d'identifier les cas potentiels liés à cette maladie pour éviter la propagation" de l'infection dans la zone euro.
Le Nord de l'Allemagne durement touché
Dans la ville de Hambourg, 300 habitants ont été infectés ou présentent des troubles pouvant être associés à une forme particulière de la bactérie. Soixante-six personnes ont déjà été hospitalisées après avoir développé des troubles graves. Dans l'ensemble de l'Allemagne, 214 cas ont été officiellement recensés alors qu'en moyenne, 50 à 60 cas sont répertoriés par an, selon le dernier bilan de l'Institut Robert-Koch. "La forme de la bactérie trouvée en Allemagne est très rare. D'ordinaire dans ce type de cas, les personnes touchées sont celles vivant sous le même toit ou allant dans la même école par exemple. Dans le cas présent, la zone touchée est beaucoup plus étendue puisqu'il s'agit du nord de l'Allemagne", explique Lisa King, épidémiologiste à l'Institut de veille sanitaire. Quelques cas suspects ont été relevés en Suède, au Royaume-Uni et aux Pays-Bas chez des personnes ayant récemment voyagé en Allemagne et sont en cours d'examen.
J.B (www.lepetitjournal.com) vendredi 27 mai 2011
Voir aussi :
Le Parisien - Concombres infectés : Bruxelles lance une alerte à la bactérie tueuse
Le Figaro - Une bactérie sème la terreur en Allemagne
Le Point - Cette bactérie qui sème la panique en Allemagne